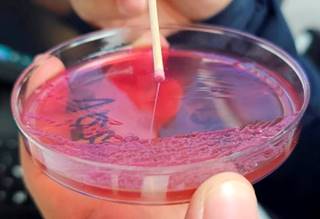

Introducción
El absceso hepático piógeno es una o múltiples colecciones de pus causado por bacterias invasivas. Las bacterias causantes más frecuentes son enterobacterias, de las cuales destaca Klebsiella pneumoniae.1 En los últimos años, se ha descrito una cepa distinta a la clásica llamada hipermucoide, que toma relevancia por adquirir factores de virulencia que pueden causar infecciones invasivas en pacientes inmunocompetentes en entornos comunitarios.2 El tratamiento incluye antibióticos y drenaje quirúrgico realizando seguimiento por estudios de imagen como ultrasonido o tomografía, así como marcadores inflamatorios para valorar la respuesta bioquímica al tratamiento.1,3 Presentamos el caso de una paciente que acudió al servicio de urgencias del Hospital Angeles Pedregal.
Presentación del caso
Mujer de 80 años con antecedente de enfermedad diverticular y viaje reciente a España. Inicia con dolor abdominal difuso de dos semanas de evolución que posteriormente se localiza en hipocondrio derecho, fiebre de 38.5 oC, hiporexia, astenia y adinamia. En el examen físico, dolor en hipocondrio derecho sin hepatomegalia. Se realiza tomografía axial computarizada (TAC) de abdomen con contraste intravenoso evidenciando abscesos hepáticos (Figura 1).

Figura 1: Tomografía de abdomen con contraste intravenoso con presencia de abscesos hepáticos de en el segmento V y VI de 84 × 78 × 66 mm en sus ejes máximos con un volumen aproximado de 206 cm3.
Estudios de laboratorio: hemoglobina 12.5 mg/dL, plaquetas 181 × 103/µL, leucocitos 17.1 × 103/µL, creatinina 1.12 mg/dL, aspartato aminotransferasa (AST) 75 U/L, alanino aminotransferasa (ALT) 80 U/L, bilirrubina total 1.70 mg/dL, bilirrubina directa 0.80 mg/dL, bilirrubina indirecta 0.90 mg/dL, fosfatasa alcalina 91 U/L, deshidrogenasa láctica 288 U/L, proteína C reactiva 214 mg/L, procalcitonina 1.6 ng/mL. Se inicia tratamiento con meropenem y daptomicina. Se tomaron hemocultivos periféricos con crecimiento positivo a las 24 horas de Klebsiella pneumoniae pansensible. A las 48 horas, se realizó drenaje percutáneo con colocación de drenaje intrahepático. Presenta desarrollo de Klebsiella pneumoniae pansensible en líquido de colección hepática con prueba de cuerda positiva (Figura 2 y Tabla 1). Se ajustó tratamiento a ceftriaxona 2 g intravenoso cada 24 horas por 28 días más, con respuesta clínica, bioquímica y radiológica completa.
Figura 2: Cultivo en agar MacConkey, con crecimiento de Klebsiella pneumoniae con prueba de cuerda positiva.
Tabla 1: Aislamiento con antibiograma del contenido de absceso hepático por VITEK 2.
| Cultivo anaerobios | |||
| Cultivo de anaerobios | Negativo | Negativo | |
| Espécimen | Absceso hepático | ||
| Cultivo de varios | |||
| Cultivo de varios | Sin desarrollo de microorganismos | ||
| Microorganismo: | |||
| Klebsiella pneumoniae | |||
| Antibiograma: | |||
| Antibiótico | CIM (µg/mL) | Interpretación | |
| Amikacina | Sensible | ||
| Ampicilina/sulbactаm | Sensible | ||
| Cefepima | Sensible | ||
| Ceftazidima | Sensible | ||
| Ceftriaxona | Sensible | ||
| Ciprofloxacino | Sensible | ||
| Ertapenem | Sensible | ||
| Gentamicina | Sensible | ||
| Imipenem | Sensible | ||
| Meropenem | Sensible | ||
| Piperacilina/tazobactam | Sensible | ||
| Tigeciclina | Sensible |
Discusión
Los abscesos hepáticos por este microorganismo presentan características fenotípicas que orientan a sospechar de esta cepa como la prueba de cuerda positiva y un patrón de susceptibilidad a todos los antimicrobianos.4
El tratamiento para los abscesos hepáticos por Klebsiella pneumoniae es drenaje quirúrgico o percutáneo cuando es posible para control de foco infeccioso y el uso concomitante de antibióticos sistémicos de acuerdo con la susceptibilidad del aislamiento microbiológico; principalmente cefalosporinas de segunda y tercera generación, fluoroquinolonas orales, sulfas o carbapenémicos. La duración del tratamiento antimicrobiano es variable siendo recomendado en la literatura su administración durante seis o hasta ocho semanas después de la resolución de foco. Por otro lado, existe una proporción de pacientes que pueden presentar recidiva siendo más frecuente en pacientes con abscesos de origen biliar en comparación con otras causas.1,3 Considerando su notable impacto epidemiológico en el ámbito mundial y el riesgo asociado de infección diseminada, resulta fundamental mantener un elevado grado de sospecha para garantizar la implementación de un tratamiento adecuado tras la confirmación del diagnóstico, con ello realizando el seguimiento pertinente.
Conclusiones
La Klebsiella pneumoniae hipermucoide, como causante de infecciones invasivas como los abscesos hepáticos, representa una amenaza epidemiológica importante y se describe con mayor frecuencia en Asia. El caso previo ejemplifica un caso característico de esta enfermedad con evolución favorable y curación con el tratamiento descrito.











 nueva página del texto (beta)
nueva página del texto (beta)


